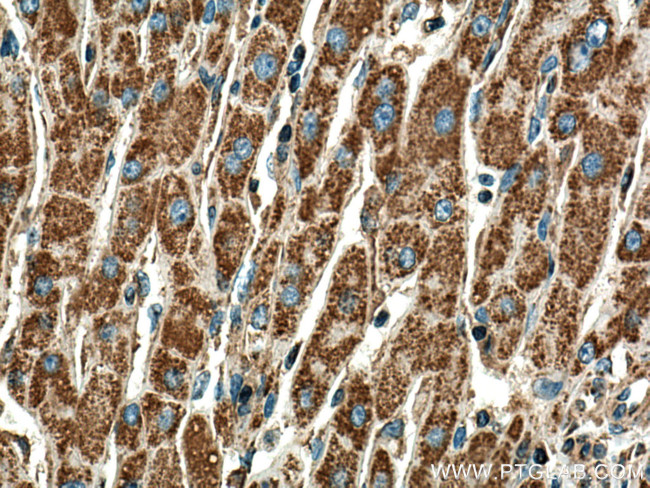
DLD Antibody in Immunohistochemistry (Paraffin) (IHC (P))

Search
Proteintech
DLD Monoclonal Antibody (2E7G5)
{{$productOrderCtrl.translations['antibody.pdp.commerceCard.promotion.promotions']}}
{{$productOrderCtrl.translations['antibody.pdp.commerceCard.promotion.viewpromo']}}
{{$productOrderCtrl.translations['antibody.pdp.commerceCard.promotion.promocode']}}: {{promo.promoCode}} {{promo.promoTitle}} {{promo.promoDescription}}. {{$productOrderCtrl.translations['antibody.pdp.commerceCard.promotion.learnmore']}}
产品信息
67702-1-IG
种属反应
宿主/亚型
分类
类型
克隆号
抗原
偶联物
形式
浓度
规格
纯化类型
保存液
内含物
保存条件
运输条件
产品详细信息
Aliquoting is unnecessary for -20°C storage.
靶标信息
This gene encodes the L protein of the mitochondrial glycine cleavage system. The L protein, also named dihydrolipoamide dehydrogenase, is also a component of the pyruvate dehydrogenase complex, the alpha-ketoglutarate dehydrogenase complex, and the branched-chain alpha-keto acide dehydrogenase complex. Mutations in this gene have been identified in patients with E3-deficient maple syrup urine disease and lipoamide dehydrogenase deficiency.
仅用于科研。不用于诊断过程。未经明确授权不得转售。
篇参考文献 (0)
生物信息学
蛋白别名: branched chain alpha-keto acid dehydrogenase complex subunit E3; diaphorase; Dihydrolipoamide dehydrogenase; dihydrolipoamide dehydrogenase (E3 component of pyruvate dehydrogenase complex, 2-oxo-glutarate complex, branched chain keto acid dehydrogenase complex); dihydrolipoamide dehydrogenase precursor; Dihydrolipoyl dehydrogenase, mitochondrial; E3 component of pyruvate dehydrogenase complex, 2-oxo-glutarate complex, branched chain keto acid dehydrogenase complex; epididymis secretory sperm binding protein; Glycine cleavage system L protein; glycine cleavage system protein L; lipoamide dehydrogenase; lipoamide dehydrogenase precursor old gene name 'LAD'; lipoamide reductase; lipoyl dehydrogenase; OTTHUMP00000206744; OTTHUMP00000206746; OTTHUMP00000206748; OTTHUMP00000206749; PH; PHE 3; pyruvate dehydrogenase complex subunit E3, 2-oxo-glutarate complex, branched chain keto acid dehydrogenase complex, glycine cleavage system protein L; unnamed protein product
基因别名: DLD; DLDD; DLDH; E3; GCSL; LAD; OGDC-E3; PHE3
UniProt ID: (Human) P09622, (Rat) Q6P6R2, (Mouse) O08749
Entrez Gene ID: (Human) 1738, (Rat) 298942, (Mouse) 13382